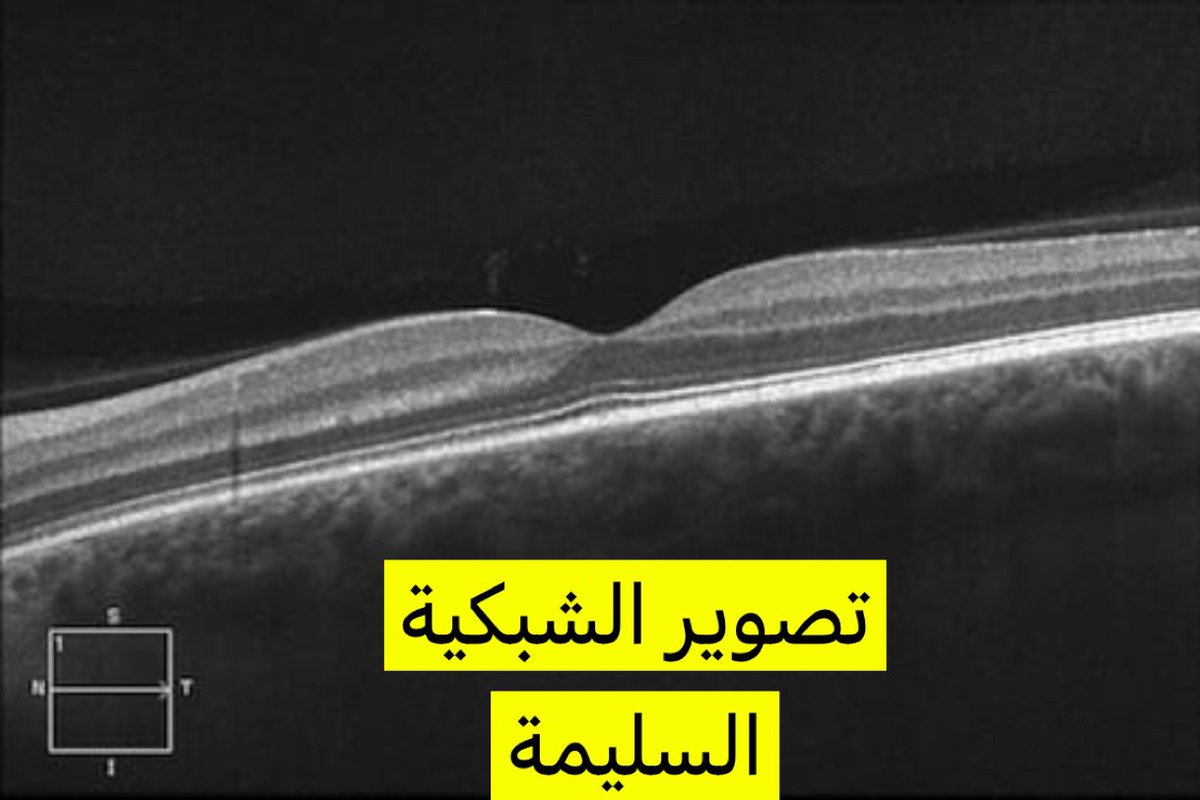

هذا الثريد لكل شخص مصاب بالسكر او شخص له قريب او عزيز مصاب بالسكر
ماهو ارتشاح الشبكية ؟ وكيفية الوقاية منه؟ و كيف يعالج؟
#صوت_الطبيب
ماهو ارتشاح الشبكية ؟ وكيفية الوقاية منه؟ و كيف يعالج؟
#صوت_الطبيب
> ارتشاح سوائل من جدار الاوعية الدموية المتضررة اساساً بسبب السكر > وجود سوائل في مركز الابصار يؤثر بشكل كبير على الرؤية قد تصل لمرحلة (العمى الشرعي) في بعض الحالات
كيف يتجنب مريض السكر هذه المضاعفات؟
الطريقة الوحيدة المثبتة للوقاية هي بالتحكم بمستوى السكر في الدم ( بشكل عام السكر التراكمي اقل من ٦.٥ )
الطريقة الوحيدة المثبتة للوقاية هي بالتحكم بمستوى السكر في الدم ( بشكل عام السكر التراكمي اقل من ٦.٥ )
(٤) الليزر للشبكية قد يكون مناسب لبعض الحالات كعلاج اضافي وليس علاج منفرد
ختاماً
اتمنى لجميع مرضى السكر الحرص على مستوى السكر في الدم، وفحص الشبكية بشكل دوري قبل طهور أي اعراض
وللتذكير، دائماً ناقش مع طبيبك الخطة العلاجية الكاملة ومعرفة الفائدة ومخاطر اي علاج قبل البدء
وبالسلامة بارب 💐
اتمنى لجميع مرضى السكر الحرص على مستوى السكر في الدم، وفحص الشبكية بشكل دوري قبل طهور أي اعراض
وللتذكير، دائماً ناقش مع طبيبك الخطة العلاجية الكاملة ومعرفة الفائدة ومخاطر اي علاج قبل البدء
وبالسلامة بارب 💐
اشكر الجميع على التفاعل مع التغريدة الله يكتب لنا ولكم فيها الاجر والمنفعة،
بالنسبة للاسئلة اللي جاتني كثيرة جداً وبارد عليها باذن الله ولكن قد اخذ عدة ايام
والاجابة لن تشمل تشخيص او خطة علاجية او (رأي آخر) لانها تتطلب فحوصات كاملة، ولكن توجيه ومساعدة باذن الله
بالنسبة للاسئلة اللي جاتني كثيرة جداً وبارد عليها باذن الله ولكن قد اخذ عدة ايام
والاجابة لن تشمل تشخيص او خطة علاجية او (رأي آخر) لانها تتطلب فحوصات كاملة، ولكن توجيه ومساعدة باذن الله
حسابات اطباء ثرية جداً ومفيدة لمرضى السكر والمهتمين بصحتهم بشكل عام (اطباء الاسرة واطباء السكر)
@ruhalaa @Dr_Aqeel16 @DrWaleedalbaker @omarnozha @drfaisalsaud @dr_raed_aldhash @DrAAB1987
(ولأي طبيب او اخصائي حسابه مفيد لمرضى السكر الرجاء التواصل على الخاص لنشر حسابه)
@ruhalaa @Dr_Aqeel16 @DrWaleedalbaker @omarnozha @drfaisalsaud @dr_raed_aldhash @DrAAB1987
(ولأي طبيب او اخصائي حسابه مفيد لمرضى السكر الرجاء التواصل على الخاص لنشر حسابه)
جاري تحميل الاقتراحات...